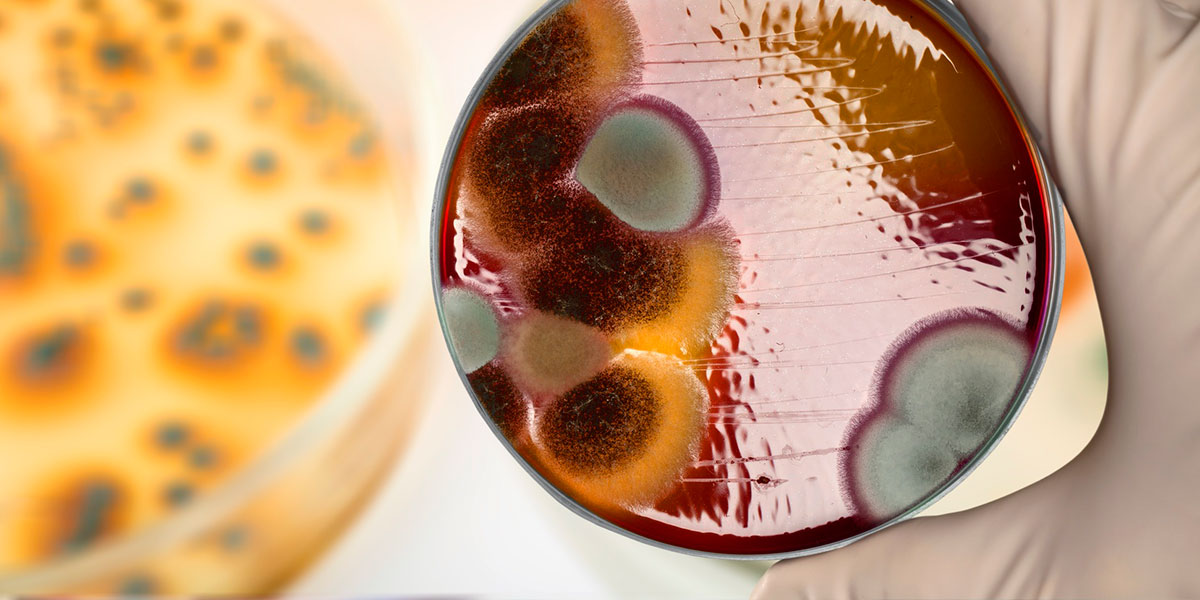

Servizi su Fotovoltaici
L’attenzione delle istituzioni verso la green economy ed il costante aumento della richiesta energetica hanno portato ad uno sfruttamento delle fonti rinnovabili con la crescente diffusione di impianti fotovoltaici collegati alla rete elettrica. La Colservice, attenta alle esigenze del mercato e forte del know-how acquisito nella risoluzione di problematiche di natura ambientale, ha investito in personale specializzato, strumentazioni e macchinari avanzati dedicati al settore del fotovoltaico. L’attenzione e la cura negli interventi rendono la Colservice partner ideale che vi consentiranno di concentrare l’attenzione sulla vostra attività, affidando alla nostra competenza tutti i servizi necessari al corretto funzionamento degli impianti.
Una delle maggiori cause di perdita nel rendimento dei pannelli fotovoltaici è lo sporco che, causato dalle polveri presenti nell’aria, dagli animali e dall’inquinamento, provoca una diminuzione nella resa stimata in circa 10-15% rispetto a quelli puliti regolarmente. Tale calo è dovuto inoltre alla lunga esposizione dei pannelli solari ai raggi ultravioletti che provocano una parziale perdita di trasparenza della patina protettiva. Per evitare ogni perdita di rendimento e sfruttare al massimo questa importante fonte di energia è necessario pulire sistematicamente i vetri dei pannelli con cadenze specifiche a seconda dell’impianto e delle caratteristiche ambientali.
La Colservice ha progettato e realizzato una serie di macchinari innovativi che garantiscono una perfetta rimozione del materiale depositato grazie al movimento meccanico delle spazzole e con utilizzo esclusivo di acqua osmotizzata. Di potenza e capacità di estensione diverse, permettono di intervenire efficacemente sia in impianti fissi che mobili. L’estrema maneggevolezza si estende ai trattamenti di pulizia di impianti integrati su pensiline di parcheggi, tettoie, facciate di edifici.
Le nostre attrezzature costituiscono la soluzione ottimale per la periodica pulizia dei moduli fotovoltaici con una convenienza superiore rispetto ai metodi tradizionali e senza impiego di prodotti chimici.